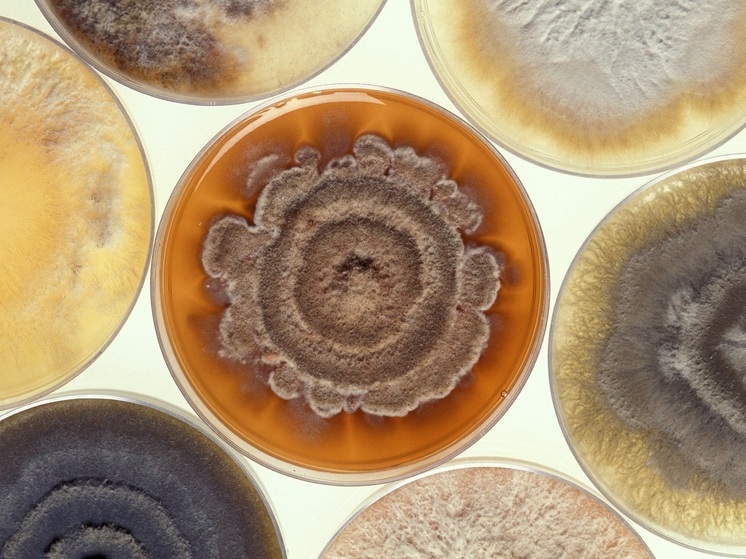

Ивановская область
Субъект Российской Федерации, входит в состав Центрального федерального округа.
Новости
-
19:46
Иран "согласился на все", сказал Трамп
-
19:42
Президент Словении назвала крупнейшую ошибку ЕС, связанную с Россией
-
19:36
Лукашенко объяснил поражение Орбана
-
19:31
Трамп сделал смелое заявление по сделке с Ираном
-
19:28
Четырехлетний ребенок застрелил младшего брата
-
12:19
17 перезапусков под вой сирен: как энергетики Белгорода выстояли в самый сложный отопительный сезон
...
Сегодня
...
...
...
...
...
Ощущается как ...
Самое интересное
-
Европа впервые со времен Второй мировой войны чувствует себя не «тылом», а линией фронта

-
«Торнадо-С» накрыли базу отдыха ВСУ: российские ракеты начали бить на опережение

-
«Ходи по облакам»: Нина Шацкая рассказала о главном жизненном принципе

-
Суд вынес новое решение по делу о разделе дома Маши Распутиной

-
«Потеря себя»: психолог выдвинула версию пропажи Героя России Асылханова в Юрге